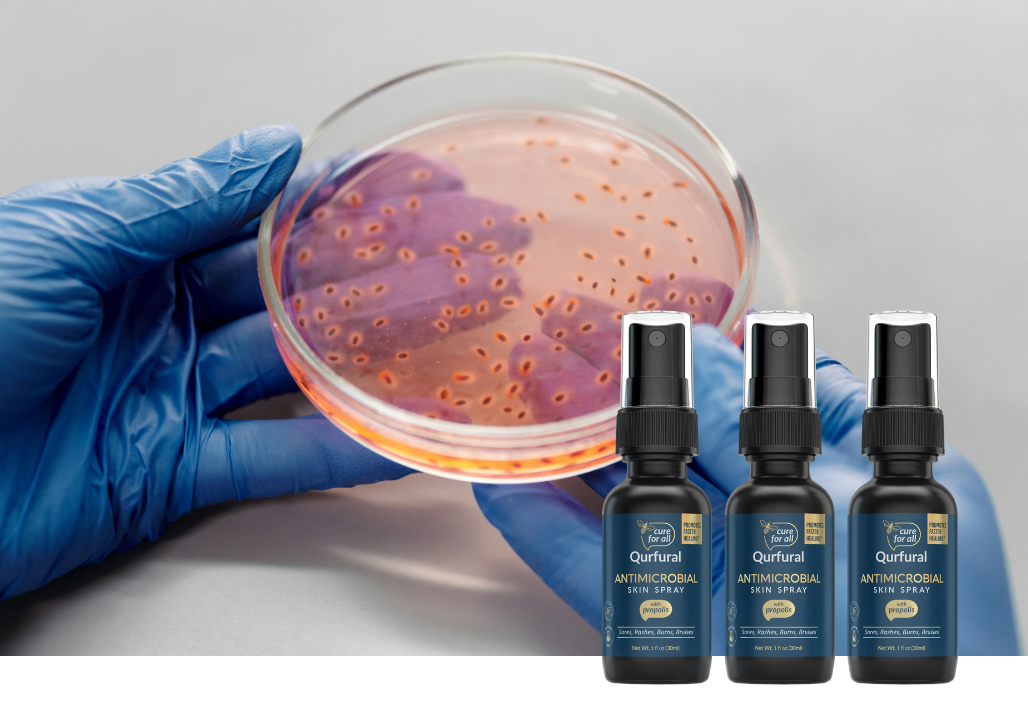

Qurfural™ Antimicrobial Skin Spray with Propolis & Hypochlorous Acid
- Regular price
-
$24.49 - Regular price
-
- Sale price
-
$24.49
Gentle, Natural Support for Sensitive Skin During Outbreaks
Find soothing comfort when your skin needs it most. Qurfural™ combines the natural protective power of propolis with hypochlorous acid, your body’s own defense molecule, to help calm irritation, reduce redness, and promote a cleaner healing environment. Alcohol-free, non-stinging, and safe for sensitive skin — ideal for supporting skin wellness during herpes outbreaks and other minor irritations.
Supports comfort during genital herpes flare-ups
Helps create a cleaner environment for skin affected by outbreaks, supporting comfort and quicker recovery from irritation.
Promotes faster-looking skin recovery
The combination of propolis and hypochlorous acid helps soothe and refresh irritated skin, encouraging its natural healing process.
Helps calm inflammation and visible redness
Formulated to reduce the look and feel of inflammation, keeping the affected area comfortable and cared for.
Provides temporary relief from pain, stinging, and itching
Offers a cooling, alcohol-free mist that eases discomfort and helps reduce sensitivity during outbreaks.
Discreet shipping and packaging
Shipped in plain, unmarked packaging to ensure your privacy and confidence.
Couldn't load pickup availability







Why Choose Qurfural
Outbreaks can be frustrating and painful. Qurfural is designed to give you peace of mind and relief you can trust.
With Propolis
A natural bee compound known for its skin-soothing and protective properties.
Antimicrobial Power
Helps fight bacteria and viruses that can worsen outbreaks.
Fine Mist Spray
Covers the affected area evenly without harsh rubbing
Alcohol Free & Gentle
Safe for sensitive skin, daily use, and repeated applications.

Qurfural
Relief When It Matters Most
Herpes outbreaks can strike suddenly, leaving behind discomfort, sores, and the worry of lasting marks.
Qurfural works to minimize the severity of outbreaks, support faster healing, and reduce the chances of scarring.
The cooling mist provides immediate soothing relief for burning, stinging, and itching — helping you feel more in control.
Powered by Nature & Science
Qurfural combines the best of natural ingredients with proven science:
Hypochlorous Acid – Your body’s own natural defense molecule, recognized for its antimicrobial properties that fight bacteria and viruses on the skin.
Propolis – A soothing, protective substance made by bees, long studied for its healing and antimicrobial effects.
This dual-action formula supports a cleaner, healthier environment for your skin so it can recover more quickly.
Testimonials
Kelly. PFinally, something alcohol-free that doesn’t sting like crazy. I keep a bottle in my bag at all times.
Amanda R.At the first sign of tingling, I sprayed Qurfural and the outbreak cleared much faster than usual.
James K.I was worried about scarring, but this spray really helped soothe my skin and speed up the healing process.

How to Use Qurfural
Relief is as simple as shake, spray, and heal.
- Shake well before use.
- Spray directly onto the affected area.
- Allow the fine mist to air dry.
- Repeat several times daily or as needed
💡 Pro Tip: Keep Qurfural with you and apply at the very first signs of an outbreak for the best results.
FAQs
Is there a cure for herpes?
There is No cure for herpes
How long do herpes sores last?
Herpes sores can last from 3-14 days
Is Qurfural worth the investment?
Qurfural spray is an investment in both you and your partners health.It was created to ease pain and discomfort and to give you peace of mind knowing that you’re using one of the most effective treatments to heal herpes sores quickly.So yes, we believe your health is worth the investment.
How does Qurfural work?
Qurfural kills bacteria and viruses to help your body heal naturally.In clinical studies, propolis was proven to provide faster relief than standard treatment options. (https://www.webmd.com/vitamins/ai/ingredientmono-390/propolis)
Is Qurfural a cure for herpes?
Qurfural spray is NOT a cure for herpes
Can I use Qurfural spray if allergic to chlorine, or bee products?
You should not use Qurfural spray if allergic to chlorine or bee products.Consult your physician if allergic symptoms develop after using Qurfural spray
Does Qurfural contain harmful chemicals?
Qurfural spray is all natural
Where can I use Qurfural?
For EXTERNAL USE ONLY! Qurfural is a topical spray
How often can I use Qurfural?
At Qurfural, we believe in being aggressive and treating herpes at the first sign of an outbreak.We recommend using as many as 3-5 times a day on the affected area.Remember Qurfural spray is safe and effective and will not harm you
Where is Qurfural made?
Qurfural spray is made in the USA.Our propolis is sourced from happy honeybees that live in Hawaii.
How should I store Qurfural?
Qurfural spray is bottled in dark bottles to protect the solution from degrading due to exposure to light. Store as normal
How should I dispose of Qurfural?
Qurfural spray is eco friendly and will not harm the environment. Dispose as normal
What’s the size of the bottle?
One (1) FL OZ
How much is shipping cost?
Shipping is free in the continental USA
How long does shipping take?
2-7 days
How can I track my order?
You will be provided with a tracking number upon order fulfillment
Is there return policy?
**30-day risk-free guarantee! Full refund of the purchase price so that you can purchase any of the competing products highlighted in comparison chart. They are the only treatment options that we recommend**
How do I get in touch if I have questions?
Contact us at questions@qurfural.com













